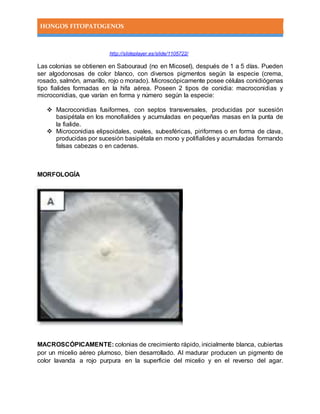
HONGOS FITOPATOGENOS
http://slideplayer.es/slide/1105722/
Las colonias se obtienen en Sabouraud (no en Micosel), después de 1 a 5 días. Pueden
ser algodonosas de color blanco, con diversos pigmentos según la especie (crema,
rosado, salmón, amarillo, rojo o morado). Microscópicamente posee células conidiógenas
tipo fialides formadas en la hifa aérea. Poseen 2 tipos de conidia: macroconidias y
microconidias, que varían en forma y número según la especie:
 Macroconidias fusiformes, con septos transversales, producidas por sucesión
basipétala en los monofialides y acumuladas en pequeñas masas en la punta de
la fialide.
 Microconidias elipsoidales, ovales, subesféricas, piriformes o en forma de clava,
producidas por sucesión basipétala en mono y polifialides y acumuladas formando
falsas cabezas o en cadenas.
MORFOLOGÍA
MACROSCÓPICAMENTE: colonias de crecimiento rápido, inicialmente blanca, cubiertas
por un micelio aéreo plumoso, bien desarrollado. Al madurar producen un pigmento de
color lavanda a rojo purpura en la superficie del micelio y en el reverso del agar.

Este documento trata sobre hongos fitopatógenos. Explica que los hongos son organismos que causan enfermedades en las plantas. Describe algunas características generales de los hongos como su reproducción a través de esporas y su nutrición heterótrofa. Además, presenta una clasificación básica de los principales géneros de hongos fitopatógenos como los chytridiales, plasmodiophorales y uredinales.